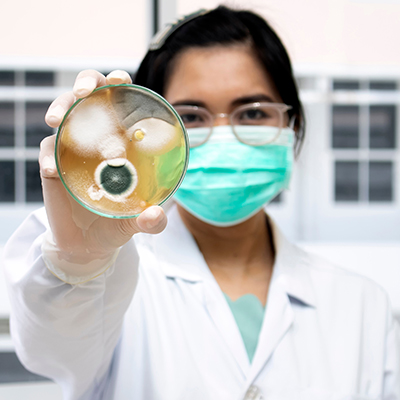

Infectious diseases
Infectious diseases
In today’s time, an individual can easily get infected with deadly viruses and infections like HIV infections, UTI infections, tropical infections, etc. Infectious diseases can be caused due to many reasons such as bacteria, viruses, animal bites, etc. At times the cause is unknown and difficult to identify, hence attention from various specialties, is needed. Infectious disease is a sub-specialty under General medicine, which works with multi-disciplinary management for accurate and effective treatments. The department aims to cure, a wide range of infections of all patients.